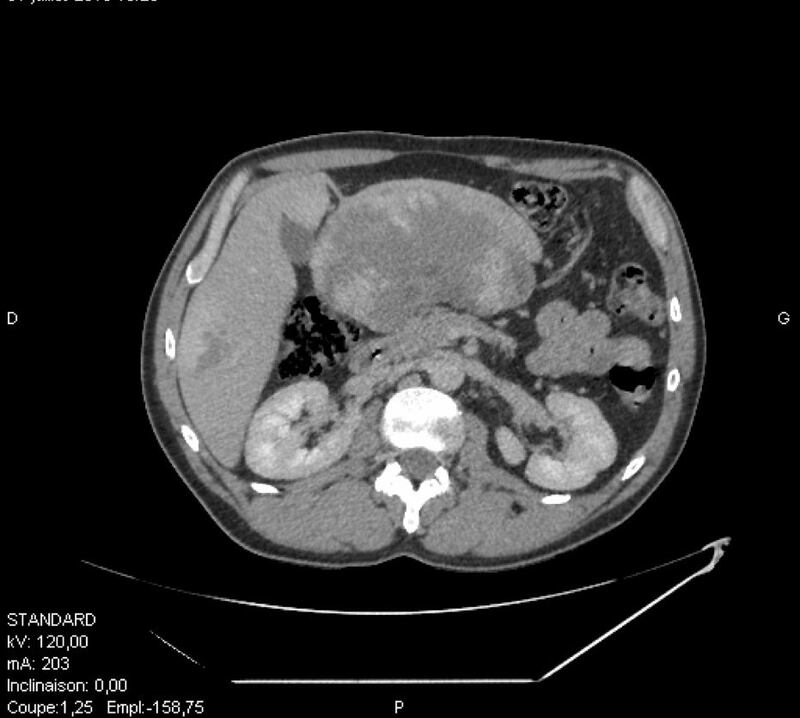
بها ورم صُنّف الأكبر عالميًا : جراح عُماني يشارك فريقًا متخصصا في تشخيص حالة نادرة جدا

مسقط – أثير
في إنجاز جديد ومتميز للشباب العماني خارج السلطنة في مجالهم العلمي والإنساني، نجح الطبيب والجراح العُماني المتدرب عبدالله بن يحيى الفرعي بمشاركة فريق من الجراحين المتخصصين في فرنسا في تشخيص حالة نادرة جداً لمريض أصيب بورم وعائي كبدي عملاق متشعب.

وجاء اكتشاف الورم للمريض الذي يعاني من إسهال وقيء وألم في منطقة أعلى البطن يزداد أثناء السعال أو الميل للأمام في قسم جراحة الأورام بمعهد باولي كالميتيس في مدينة مرسيليا الفرنسية حيث يتدرب ويعمل الفرعي وصُنف الورم كأكبر ورم على مستوى العالم ضمن 19 حالة مسجلة بدقة عالمياً ومنشورة في الدوريات العلمية.

وكان المريض قد راجع المستشفى بعد تعرضه لآلام حادة في البطن في العمل قبل شهر واحد من حضوره، حيث كشف الفحص السريري عن كتلة كبيرة واضحة في البطن تحتل معظم المنطقة الشرسوفية الشريانية اليمنى “أعلى ويمين البطن”. كانت اختبارات الدم طبيعية تقريبا، وأظهر التصوير بالموجات الصوتية للبطن كتلة ضخمة غير متجانسة (18 × 10 سم) تقع في المنطقة الشرسوفية أمام البانكرياس وتتسب بضغط على الفص الأيسر للكبد باتجاه الأمام. وأظهر المسح المقطعي المحسّن للتجويف الحوضي والبطني وجود ورم نسيجي هائل أمام البانكرياس بقياس حوالي 20 × 9 × 16 سم.
وبحسب “الفرعي” لم يكن لدى المريض تاريخ مرضي ضمن العائلة باستثناء الربو، فضلاً عن التدخين، إلا أن الفحوصات السريرية أكدت وجود الورم فتقرر تحويل الحالة إلى مجلس الأورام متعدد التخصصات، حيث تأكد وجود ورم وعائي كبدي عملاق من النوع المتشعب الأكثر ندرة في العالم، وهذا النوع من الأورام الحميدة يصعب تشخيصها للغاية بسبب طريقة نموها خارج المنطقة المصابة بشكل متشعب يشبه إلى حد ما جذور النباتات.
وأضاف الدكتور : هنا أخذنا القرار بإجراء تصوير بالرنين المغناطيسي للكبد لتأتي النتائج لتظهر وجود العديد من الأورام الوعائية المنتشرة في جميع أنحاء الكبد بعد الحقن بصبغة تظهر التباين في الأورام. الورم الأكبر حجما هو ورم وعائي متشعب نشأ من الجزء الكبدي الثالث، مع تطور خارجي “التنبت” في المنطقة الشرسوفية يدفع البنكرياس إلى الوراء. أبعاد الورم 20 × 8 × 14 سم وهو يُعد الأضخم ضمن الحالات المسجلة عالمياً، كان هناك خطر بحصول التواء أو تمزق للورم يعقد من الحالة، ولذلك تم أخذ القرار بإجراء استئصال جراحي دون أخذ “خزعة” من الورم مسبقاً، وبالفعل قمنا بإجراء العملية الجراحية واستئصال الفص الأيسر للكبد المصاب دون أية آثار جانبية، وخرج المريض من المستشفى في اليوم الرابع بعد العملية الجراحية، حيث شارك في هذه العملية الجراحية فريق من ثلاثة جراحين متخصصين”.
وعن تجربته ومشاركته في هذا العمل قال الفرعي : “لقد كانت تجربة استثنائية مثرية، حيث أن تكون ضمن الفريق الجراحي المسؤول عن حالة غاية في الندرة على مستوى العالم ليس بالشأن اليسير، ويوجد 19 حالة فقط على مستوى العالم تم توثيقها للأورام الكبدية الوعائية العملاقة، والحالة التي شاركت بعلاجها هي الأكبر بين تلك الحالات، مما يجعلها حالة مرجعية حول العالم، وقد قمنا بوضع تقرير تفصيلي للحالة للاستعانة به من قبل المتخصصين حول العالم، ويشرفني أن يكون اسمي ضمن المجموعة الضيقة التي أشرفت على التقرير”.
جدير بالذكر أن الدكتور عبدالله بن يحيى الفرعي أحد خريجي كلية الطب والعلوم الصحية بجامعة السلطان قابوس وقد شارف على إنهاء تخصص الجراحة العامة/الباطنية في جامعة أكس مرسيليا الفرنسية ويستعد لبدء التخصص الدقيق في جراحة الكبد والبانكرياس في قسم جراحة الأورام بمعهد باولي كالميتيس في مدينة مرسيليا الفرنسية.




